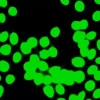

₹1,100.00
Add to cartANCA MPO (p-ANCA)
₹1,100.00
Add to cart
Buy Now
-
Ask a Question
Ask a Question
ANCA MPO (p-ANCA)
₹1,100.00
Category: SPECIAL TEST
Guaranteed Safe Checkout
Free
Worldwide Shopping
100%
Guaranteed Satisfaction
30 Day
Guaranteed Money Back

Reviews
There are no reviews yet.